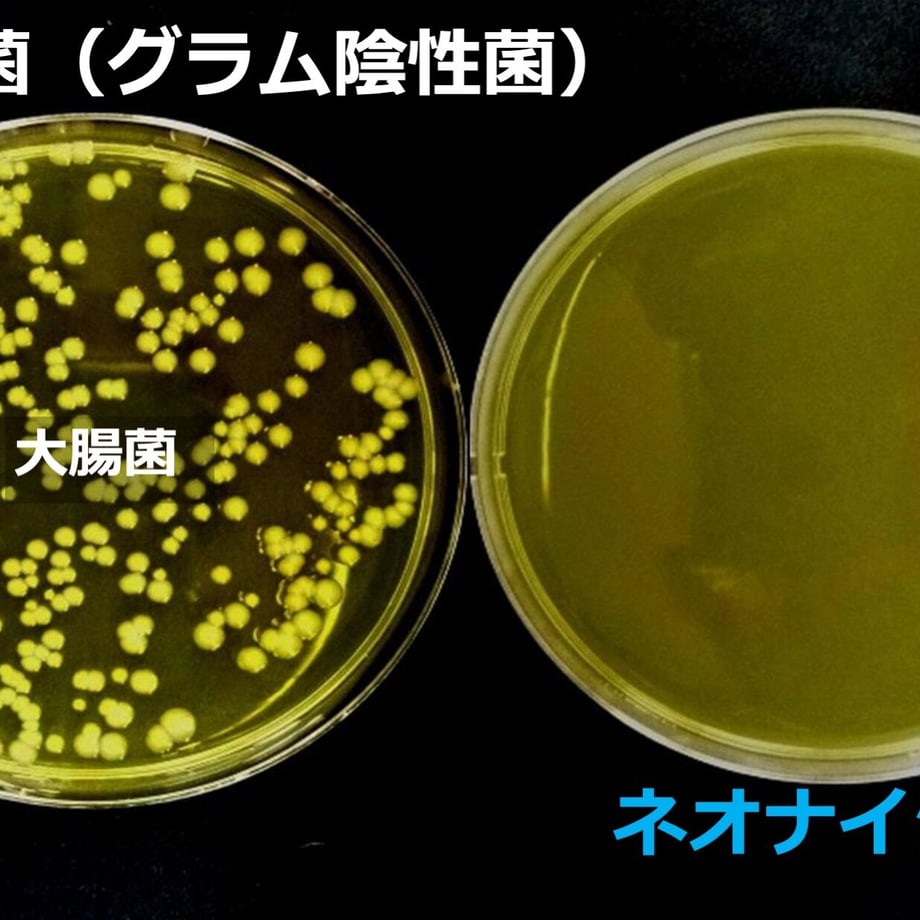

商品カテゴリ
オリジナル商品はこちら
アイテム
- インスタグラム掲載商品
- SALE 商品
- 店主の掘り出し棚
- レンタル
- ながのキャンパルORIGINAL
- テント・タープ
- 寝袋(シュラフ)・枕・コット
- ハンモック
- テーブル・チェア・スタンド
- ランタン・ライト
- ヒーティング
- 焚火台・BBQ
- クッキング用品
- 食器・カトラリー
- 収納ケース・カバー
- ポータブル電源・ソーラーパネル
- クーラーボックス・ジャグ
- メンテナンス・リペア
- アクセサリー
- フィールドギア
- アクティビティ
- Tシャツ
- 調味料
-
ブランドALL
- Abenteuer|アーベントイアー
- ALDEBARAN|アルデバラン
- ANCAM|アナキャン
- ANOBA|アノバ
- anymaka | エニーマカ
- AO Coolers|エーオークーラーズ
- asimocrafts|アシモクラフツ
- arata|アラタ
- AIR SCAPE|エアスケープ
- AS20V|アッソブ
- ASOBU|アソブ
- asobito|アソビト
- ASOMATOUS | アソマタス
- AMICAL Schlaf|アミカルシュラフ
- BACKCOUNTRY|バックカントリー
- Ballistics|バリスティクス
- BAREBONES|ベアボーンズ
- Belmont|ベルモント
- BIG FOREST|ビッグフォレスト
- BOOS|ボース
- BOUNDARY LINE|バウンダリーライン
- Bush Craft Inc|ブッシュクラフト
- BUSHMEN|ブッシュメン
- BRENNHOLZ|ブレンホルツ
- COLONISTA|コロニスタ
- COCOpan|ココパン
- COUNTER ASSAULT|カウンターアソールト
- C&C.P.H.EQUIPEMENT|シーアンドシーピーエイチ
- Caframo|カフラモ
- CAME DE CAME|カムデカム
- Camerons|キャメロンズ
- CAMP GEEKS|キャンプギークス
- CARGO container|カーゴコンテナー
- CARL HOERECKE|カールホーネック
- CLAYMORE|クレイモア
- COGHLAN'S|コフラン
- COLAPZ|コラプズ
- Coleman|コールマン
- Cook’n’Ecsape|クックンエスケープ
- cores|コレス
- conifer cone|コニファーコーン
- COOLER SHOCK|クーラーショック
- corerocca|コレロッカ
- CAFEC | カフェック
- DALUM|ダーラム
- CHOPLATE|チョップレート
- DELTA/MT|デルタエムティ
- deuter|ドイター
- DETAIL|ディテール
- DIETZ|デイツ
- DUCKNOT|ダックノット
- DRAFT TOP|ドラフトトップ
- EAGLE Products|イーグルプロダクツ
- EIGHT|エイト
- Elk Ridge|エルクリッジ
- eno|イーノ
- E.N Works|エンワークス
- EPIgas|イーピーアイガス
- Esbit|エスビット
- escargot|エスカルゴ
- EVERNEW|エバニュー
- FAIRWEATHER|フェアウェザー
- Fallworks|フォルワークス
- FEDECA|フェデカ
- Fellow|フェロー
- FEUERHAND|フュアハンド
- FicxMoC|フィックモック
- FIRELIGHERS|ファイヤーライターズ
- Fire-Maple |ファイヤーメープル
- FIRESIDE|ファイヤーサイド
- FOG|フォグ
- FOLBOT |フォルボット
- FORESTABLE OUTDOOR|フォレスタブルアウトドア
- FLEXTAIL|フレックステイル
- GARELLA 'EKAHI WORKS|ガレラエカヒワークス
- GEAR AID|ギアエイド
- GLOW STICKS|グロースティックス
- Goal Zero|ゴールゼロ
- GOLDEN MUSTARD|ゴールデンマスタード
- GRANSFORS BRUKUS|グレンスフォシュブルーク
- GREEN MOTION|グリーンモーション
- ground cover|グラウンドカバー
- GSI|ジーエスアイ
- GRACE|グレイス
- GOEN|ゴエン
- grn|ジーアールエヌ
- GREBE WORKS|グリーブワークス
- HALF TRACK PRODUCTS|ハーフトラックプロダクツ
- Hang Out|ハングアウト
- H.A.K.U | ハク
- Helinox|ヘリノックス
- Helsport|ヘルスポート
- HELLE|ヘレ
- HEXAR|ヘキサ―
- HIGHMOUNT|ハイマウント
- Hilander|ハイランダー
- HILLS FIELD|ヒルズフィールド
- Hultafors|ハルタホース
- HiHæk|ハイヘイク
- HIGH FIVE | ハイファイブ
- HINODEYA|ヒノデヤ
- ICECO|アイスコ
- ISUKA|イスカ
- injinji|インジンジ
- INAVANCE|インアバンス
- IMCO|イムコ
- ino/uto|イノウト
- IWATADENKI|イワタデンキ
- Iwatani|イワタニ
- JHQ|ジェイエイチキュー
- Jokos Factory
- KAARI|カーリ
- KALUGII|カルギイ
- KARCHER|ケルヒャー
- KARLSKRONA LAMPFABRIK|カールスクローナ
- KAVU|カブー
- Kermit Chair|カーミットチェア
- KIKKERLAND|キッカーランド
- keith|キース
- KINCO|キンコ
- KZM OUTDOOR|カズミアウトドア
- LANSKY|ランスキー
- Lawson Hammock|ローソンハンモック
- LEDLENSER|レッドレンザー
- LEKKER|レッカー
- LEISMOR|レイズモア
- Libelle|リベル
- LighterBro|ライターブロ
- LIFE SYSTEMS|ライフシステム
- LOD PRODUCTS|ロッドプロダクツ
- LUGH|ルー
- M tech USA|エムテックUSA
- Mac Outdoor|マックアウトドア
- Matador|マタドール
- MALAIKA|マライカ
- Mardouro|マルドウロ
- MIGRATRAIL|ミグラトレイル
- mind|マインド
- MINERVA|ミネルヴァ
- MINIMAL WORKS|ミニマルワークス
- MOFMA|モフマ
- MOBI GARDEN|モビガーデン
- MOG|モグ
- Moment of Truth(MOT)|モーメント オブ トゥルース(モット)
- The mountain commons|マウンテンコモンズ
- MSR|エムエスアール
- Mt.SUMI|マウントスミ
- MTM japan|エムティーエムジャパン
- MOOSE ROOM WORKS | ムースルームワークス
- MOLKKY | モルキー
- NATURE TONES|ネイチャートーンズ
- nalgene|ナルゲン
- NANGA|ナンガ
- NATURAL MOUNTAIN MONKEYS|ナチュラルマウンテンモンキーズ
- NESTOUT|ネストアウト
- newAlpaca|ニューアルパカ
- Nordisk|ノルディスク
- Nor Tent|ノルテント
- NUMA|ヌーマ
- NUTS OUTDOOR|ナッツアウトドア
- ogawa|オガワ
- OLD MOUNTAIN|オールドマウンテン
- OLGHT|オーライト
- Onway|オンウェー
- Ooni|ウニ
- OPINEL|オピネル
- OPTIMUS|オプティマス
- Oregonian Camper|オレゴニアンキャンパー
- ORTLIEB|オルトリーブ
- ORU KAYAK|オルカヤック
- OUTDOOR LIFE|アウトドアライフ
- OUTDOOR RESEARCH|アウオドアリサーチ
- OUTSIDE IN|アウトサイドイン
- OWL CAMP|アウルキャンプ
- OWL MILS|アウルミルズ
- ORALMOUNTAIN |オーラルマウンテン
- OCTAGON|オクタゴン
- ORIGAMI | オリガミ
- PASECO|パセコ
- Petromax|ペトロマックス
- platypus|プラティパス
- Platchamp|プラットチャンプ
- POST GENERAL|ポストジェネラル
- PRESSOL|プレッソル
- Pre Tents|プレテント
- PRIMUS|プリムス
- PENDLETON|ペンドルトン
- POMOLY|ポモリー
- PowerArQ|パワーアーク
- QUICK CAMP|クイックキャンプ
- RELAX|リラックス
- Release|リレース
- Ridge monkey|リッジモンキー
- RIVERS|リバーズ
- ROBENS|ローベンス
- sanzoku mountain|サンゾクマウンテン
- SANZOKU PRODUCTS|サンゾクプロダクツ
- Sawyer|ソーヤー
- SINANO WORKS|シナノワークス
- slow hours|スローアワーズ
- Snugpak|スナグパック
- Seirus|セイラス
- SO9|エスオーナイン
- SomAbito|ソマビト
- sosogu_|ソソグ
- SOTO|ソト
- SOTO Labo|ソトラボ
- STANLEY|スタンレー
- STAR Fuel|スターフューエル
- sangi|サンギ
- SHIMANO|シマノ
- SOL|エスオーエル
- SOLO STOVE|ソロストーブ
- Suffix|サフィックス
- tab.|タブ
- TAC-FORCE|タックフォース
- TAC✩FIGHTER|タックファイター
- TARU HORIC|タルホリック
- The Free Spirits Tents-自由之魂-|フリースピリッツ
- THE PERFECT bungee|パーフェクトバンジー
- THERMAREST|サーマレスト
- ThermaSeat|サーマシート
- THERMOS|サーモス
- THINKER|シンカー
- trangia|トランギア
- TRIPATH PRODUCTS|トリパスプロダクツ
- TRUSCO|トラスコ
- _
- TOKYO CRAFTS|トーキョークラフツ
- TSUNOKAWAFARM|ツノカワファーム
- T→commit®︎Ploduct|ティコミットプロダクト
- UCO|ユーコ
- UNIFLAME|ユニフレーム
- unu's|ウーヌス
- VARGO|バーゴ
- Vapalux|ヴェイパラックス
- VENTLAX|ヴェントラクス
- VERMONT LANTERNS|バーモントランタン
- VOVA|ヴォヴァ
- WAQ |ワック
- WILD THINGS|ワイルドシングス
- WEEKEND/ER|ウィークエンダー
- Wood and Burn|ウッドアンドバーン
- Wool power|ウールパワー
- WHAT NOT|ワットノット
- YARD|ヤード
- YODELL|ヨーデル
- YOKA|ヨカ
- ZASSENHAUS|ザッセンハウス
- ZIVETALIAN|ジベタリアン
- 10 to 10|点と点
- 38explore
- 5050 WORKSHOP|フィフティフィフティワークショップ
- 吾妻食品
- オムニ石油バーナー
- 貝原バーナー
- 鎌倉天幕
- カメディ
- カメヤマキャンドルハウス
- カンエイ産業
- コケナワ
- 児玉兄弟商会
- 太陽|タイヨウ
- 高桑金属
- 武井バーナー
- サンコー
- サンゾー工務店
- 沢田テント
- タンゲ化学工業
- 燕三条キッチン研究所
- 刀吉(To-kichi)
- ドクターヘッセル
- ナチュラルケミストリーラボ
- 野良道具製作所
- ハナモモ
- バイオ科学
- 福善|フクゼン
- フジノハガネ
- ペガサスキャンドル
- ほりにし
- 槙塚鉄工所
- マルカ
- 山旅|ヤマタビ
- ルナテック
- _
ブランド
- Abenteuer|アーベントイアー
- ALDEBARAN|アルデバラン
- ANCAM|アナキャン
- ANOBA|アノバ
- anymaka | エニーマカ
- AO Coolers|エーオークーラーズ
- asimocrafts|アシモクラフツ
- arata|アラタ
- AIR SCAPE|エアスケープ
- AS20V|アッソブ
- ASOBU|アソブ
- asobito|アソビト
- ASOMATOUS | アソマタス
- AMICAL Schlaf|アミカルシュラフ
- BACKCOUNTRY|バックカントリー
- Ballistics|バリスティクス
- BAREBONES|ベアボーンズ
- Belmont|ベルモント
- BIG FOREST|ビッグフォレスト
- BOOS|ボース
- BOUNDARY LINE|バウンダリーライン
- Bush Craft Inc|ブッシュクラフト
- BUSHMEN|ブッシュメン
- BRENNHOLZ|ブレンホルツ
- COLONISTA|コロニスタ
- COCOpan|ココパン
- COUNTER ASSAULT|カウンターアソールト
- C&C.P.H.EQUIPEMENT|シーアンドシーピーエイチ
- Caframo|カフラモ
- CAME DE CAME|カムデカム
- Camerons|キャメロンズ
- CAMP GEEKS|キャンプギークス
- CARGO container|カーゴコンテナー
- CARL HOERECKE|カールホーネック
- CLAYMORE|クレイモア
- COGHLAN'S|コフラン
- COLAPZ|コラプズ
- Coleman|コールマン
- Cook’n’Ecsape|クックンエスケープ
- cores|コレス
- conifer cone|コニファーコーン
- COOLER SHOCK|クーラーショック
- corerocca|コレロッカ
- CAFEC | カフェック
- DALUM|ダーラム
- CHOPLATE|チョップレート
- DELTA/MT|デルタエムティ
- deuter|ドイター
- DETAIL|ディテール
- DIETZ|デイツ
- DUCKNOT|ダックノット
- DRAFT TOP|ドラフトトップ
- EAGLE Products|イーグルプロダクツ
- EIGHT|エイト
- Elk Ridge|エルクリッジ
- eno|イーノ
- E.N Works|エンワークス
- EPIgas|イーピーアイガス
- Esbit|エスビット
- escargot|エスカルゴ
- EVERNEW|エバニュー
- FAIRWEATHER|フェアウェザー
- Fallworks|フォルワークス
- FEDECA|フェデカ
- Fellow|フェロー
- FEUERHAND|フュアハンド
- FicxMoC|フィックモック
- FIRELIGHERS|ファイヤーライターズ
- Fire-Maple |ファイヤーメープル
- FIRESIDE|ファイヤーサイド
- FOG|フォグ
- FOLBOT |フォルボット
- FORESTABLE OUTDOOR|フォレスタブルアウトドア
- FLEXTAIL|フレックステイル
- GARELLA 'EKAHI WORKS|ガレラエカヒワークス
- GEAR AID|ギアエイド
- GLOW STICKS|グロースティックス
- Goal Zero|ゴールゼロ
- GOLDEN MUSTARD|ゴールデンマスタード
- GRANSFORS BRUKUS|グレンスフォシュブルーク
- GREEN MOTION|グリーンモーション
- ground cover|グラウンドカバー
- GSI|ジーエスアイ
- GRACE|グレイス
- GOEN|ゴエン
- grn|ジーアールエヌ
- GREBE WORKS|グリーブワークス
- HALF TRACK PRODUCTS|ハーフトラックプロダクツ
- Hang Out|ハングアウト
- H.A.K.U | ハク
- Helinox|ヘリノックス
- Helsport|ヘルスポート
- HELLE|ヘレ
- HEXAR|ヘキサ―
- HIGHMOUNT|ハイマウント
- Hilander|ハイランダー
- HILLS FIELD|ヒルズフィールド
- Hultafors|ハルタホース
- HiHæk|ハイヘイク
- HIGH FIVE | ハイファイブ
- HINODEYA|ヒノデヤ
- ICECO|アイスコ
- ISUKA|イスカ
- injinji|インジンジ
- INAVANCE|インアバンス
- IMCO|イムコ
- ino/uto|イノウト
- IWATADENKI|イワタデンキ
- Iwatani|イワタニ
- JHQ|ジェイエイチキュー
- Jokos Factory
- KAARI|カーリ
- KALUGII|カルギイ
- KARCHER|ケルヒャー
- KARLSKRONA LAMPFABRIK|カールスクローナ
- KAVU|カブー
- Kermit Chair|カーミットチェア
- KIKKERLAND|キッカーランド
- keith|キース
- KINCO|キンコ
- KZM OUTDOOR|カズミアウトドア
- LANSKY|ランスキー
- Lawson Hammock|ローソンハンモック
- LEDLENSER|レッドレンザー
- LEKKER|レッカー
- LEISMOR|レイズモア
- Libelle|リベル
- LighterBro|ライターブロ
- LIFE SYSTEMS|ライフシステム
- LOD PRODUCTS|ロッドプロダクツ
- LUGH|ルー
- M tech USA|エムテックUSA
- Mac Outdoor|マックアウトドア
- Matador|マタドール
- MALAIKA|マライカ
- Mardouro|マルドウロ
- MIGRATRAIL|ミグラトレイル
- mind|マインド
- MINERVA|ミネルヴァ
- MINIMAL WORKS|ミニマルワークス
- MOFMA|モフマ
- MOBI GARDEN|モビガーデン
- MOG|モグ
- Moment of Truth(MOT)|モーメント オブ トゥルース(モット)
- The mountain commons|マウンテンコモンズ
- MSR|エムエスアール
- Mt.SUMI|マウントスミ
- MTM japan|エムティーエムジャパン
- MOOSE ROOM WORKS | ムースルームワークス
- MOLKKY | モルキー
- NATURE TONES|ネイチャートーンズ
- nalgene|ナルゲン
- NANGA|ナンガ
- NATURAL MOUNTAIN MONKEYS|ナチュラルマウンテンモンキーズ
- NESTOUT|ネストアウト
- newAlpaca|ニューアルパカ
- Nordisk|ノルディスク
- Nor Tent|ノルテント
- NUMA|ヌーマ
- NUTS OUTDOOR|ナッツアウトドア
- ogawa|オガワ
- OLD MOUNTAIN|オールドマウンテン
- OLGHT|オーライト
- Onway|オンウェー
- Ooni|ウニ
- OPINEL|オピネル
- OPTIMUS|オプティマス
- Oregonian Camper|オレゴニアンキャンパー
- ORTLIEB|オルトリーブ
- ORU KAYAK|オルカヤック
- OUTDOOR LIFE|アウトドアライフ
- OUTDOOR RESEARCH|アウオドアリサーチ
- OUTSIDE IN|アウトサイドイン
- OWL CAMP|アウルキャンプ
- OWL MILS|アウルミルズ
- ORALMOUNTAIN |オーラルマウンテン
- OCTAGON|オクタゴン
- ORIGAMI | オリガミ
- PASECO|パセコ
- Petromax|ペトロマックス
- platypus|プラティパス
- Platchamp|プラットチャンプ
- POST GENERAL|ポストジェネラル
- PRESSOL|プレッソル
- Pre Tents|プレテント
- PRIMUS|プリムス
- PENDLETON|ペンドルトン
- POMOLY|ポモリー
- PowerArQ|パワーアーク
- QUICK CAMP|クイックキャンプ
- RELAX|リラックス
- Release|リレース
- Ridge monkey|リッジモンキー
- RIVERS|リバーズ
- ROBENS|ローベンス
- sanzoku mountain|サンゾクマウンテン
- SANZOKU PRODUCTS|サンゾクプロダクツ
- Sawyer|ソーヤー
- SINANO WORKS|シナノワークス
- slow hours|スローアワーズ
- Snugpak|スナグパック
- Seirus|セイラス
- SO9|エスオーナイン
- SomAbito|ソマビト
- sosogu_|ソソグ
- SOTO|ソト
- SOTO Labo|ソトラボ
- STANLEY|スタンレー
- STAR Fuel|スターフューエル
- sangi|サンギ
- SHIMANO|シマノ
- SOL|エスオーエル
- SOLO STOVE|ソロストーブ
- Suffix|サフィックス
- tab.|タブ
- TAC-FORCE|タックフォース
- TAC✩FIGHTER|タックファイター
- TARU HORIC|タルホリック
- The Free Spirits Tents-自由之魂-|フリースピリッツ
- THE PERFECT bungee|パーフェクトバンジー
- THERMAREST|サーマレスト
- ThermaSeat|サーマシート
- THERMOS|サーモス
- THINKER|シンカー
- trangia|トランギア
- TRIPATH PRODUCTS|トリパスプロダクツ
- TRUSCO|トラスコ
- _
- TOKYO CRAFTS|トーキョークラフツ
- TSUNOKAWAFARM|ツノカワファーム
- T→commit®︎Ploduct|ティコミットプロダクト
- UCO|ユーコ
- UNIFLAME|ユニフレーム
- unu's|ウーヌス
- VARGO|バーゴ
- Vapalux|ヴェイパラックス
- VENTLAX|ヴェントラクス
- VERMONT LANTERNS|バーモントランタン
- VOVA|ヴォヴァ
- WAQ |ワック
- WILD THINGS|ワイルドシングス
- WEEKEND/ER|ウィークエンダー
- Wood and Burn|ウッドアンドバーン
- Wool power|ウールパワー
- WHAT NOT|ワットノット
- YARD|ヤード
- YODELL|ヨーデル
- YOKA|ヨカ
- ZASSENHAUS|ザッセンハウス
- ZIVETALIAN|ジベタリアン
- 10 to 10|点と点
- 38explore
- 5050 WORKSHOP|フィフティフィフティワークショップ
- 吾妻食品
- オムニ石油バーナー
- 貝原バーナー
- 鎌倉天幕
- カメディ
- カメヤマキャンドルハウス
- カンエイ産業
- コケナワ
- 児玉兄弟商会
- 太陽|タイヨウ
- 高桑金属
- 武井バーナー
- サンコー
- サンゾー工務店
- 沢田テント
- タンゲ化学工業
- 燕三条キッチン研究所
- 刀吉(To-kichi)
- ドクターヘッセル
- ナチュラルケミストリーラボ
- 野良道具製作所
- ハナモモ
- バイオ科学
- 福善|フクゼン
- フジノハガネ
- ペガサスキャンドル
- ほりにし
- 槙塚鉄工所
- マルカ
- 山旅|ヤマタビ
- ルナテック
- _

オーラルピース フォーペット80g歯磨き口腔ケアジェル
ネコポス 全国一律 385円(税込)
✨ 3,300円(税込)以上で送料無料
※対象商品のみ・ポスト投函
宅配便送料:地域別
▶ 地域別送料一覧を表示する
| 配送地域 | 送料(税込) |
|---|---|
| 関東・信越・東海・北陸 | 880円 |
| 関西 | 990円 |
| 東北・中国 | 1,100円 |
| 四国 | 1,200円 |
| 北海道・九州 | 1,320円 |
| 沖縄 | 3,300円 |
🚚 11,000円(税込)以上で送料無料
※一部例外商品がございます。ご了承ください。
※沖縄・離島は送料無料対象外(別途中継料)となります。
・犬・猫の毎日の口腔ケアに使いやすい、ジェルタイプの歯みがき・口腔ケアアイテムです。
・特許製剤「ネオナイシン-e®︎」配合。天然由来成分100%のまま、手に取りやすいジェル状で、犬が喜びやすい味わいと使いやすさを目指してリニューアルされています。
・歯ブラシや指サック、ガーゼで塗布しやすく、すすぎ不要。噛んで歯を磨けるタイプのおもちゃと一緒に使う方法も案内されています。
・飲み水に少量混ぜる使い方にも対応しており、歯みがきが苦手な子の口腔ケア習慣づくりにも取り入れやすいアイテムです。
【こんな方におすすめ】
・愛犬、愛猫の口臭やお口の汚れが気になる方
・歯みがきを嫌がりやすく、やさしく続けられる口腔ケアを探している方
・すすぎ不要で使いやすい、犬猫用の歯みがきジェルを探している方
・天然由来成分のペット用オーラルケア用品を選びたい方
【仕様】
・内容量:80g(約2か月分)
・タイプ:犬猫用歯みがきジェル
・使用方法:歯ブラシや指サックに適量(約1センチ)を取りブラッシング、または清潔な指やガーゼで口腔内に塗布
・すすぎ:不要
・全成分:グリセリン、水、乳酸球菌培養エキス、キサンタンガム、ウメ果実エキス、カエサルピニアスピノサガム、セイヨウハッカ油、スペアミント油、ダマスクバラ花油
【ご注意】
・飲み水に混ぜたり塗布したりする使い方も案内されていますが、口臭や歯垢、歯石対策はブラッシングなどの物理的な清掃が基本です。
・ペットの飲み水に使用する場合は、1日1回は新しい水に替えることが案内されています。
販売価格について
販売価格は、表示された金額(表示価格/消費税込)といたします。
お支払い方法
お支払い方法は以下の方法がご選択いただけます。
・クレジット支払い
当店では「イプシロン株式会社」のカード決済システムを導入しています。
ご利用可能なカードは下記のとおりです。

・PayPay
・代金引換
・銀行振込
送料・配送について
・地域別に別途配送料がかかります。送料はご指定の配送先に応じてカート画面にて自動で計算されます。
・大型商品につきましては個別送料となります。
ご注文確認後7日営業日以内に発送いたします。
悪天候や大型連休期間は配送に遅れが生じることがございます。
また、当店の休業日や臨時休業日は商品の発送やお問い合わせはお休みさせていただきます。
万が一商品の在庫不足や諸般の事情により配送が遅れる場合はお客様にご連絡致します。
配送時間帯の指定について
ご注文の際に「ご注文手続き」のページにてご希望の「お届け時間帯」を選択してください。
※悪天候や交通事情等によりご希望にそえない場合もございます。
※時間指定ではございません。ご希望時間帯の範囲内での配送となります。
商品のキャンセルについて
必ずお電話にてご連絡下さい。発送前であれば期限を設けることなくキャンセルを承ります。
返品について
お客様の都合による返品は、原則お受け出来ません。
万が一不良品や品違いがあった場合は、商品到着後7日以内に当店にご連絡の上、送料着払いで返品ください。
お問い合わせ先
お問い合わせ







